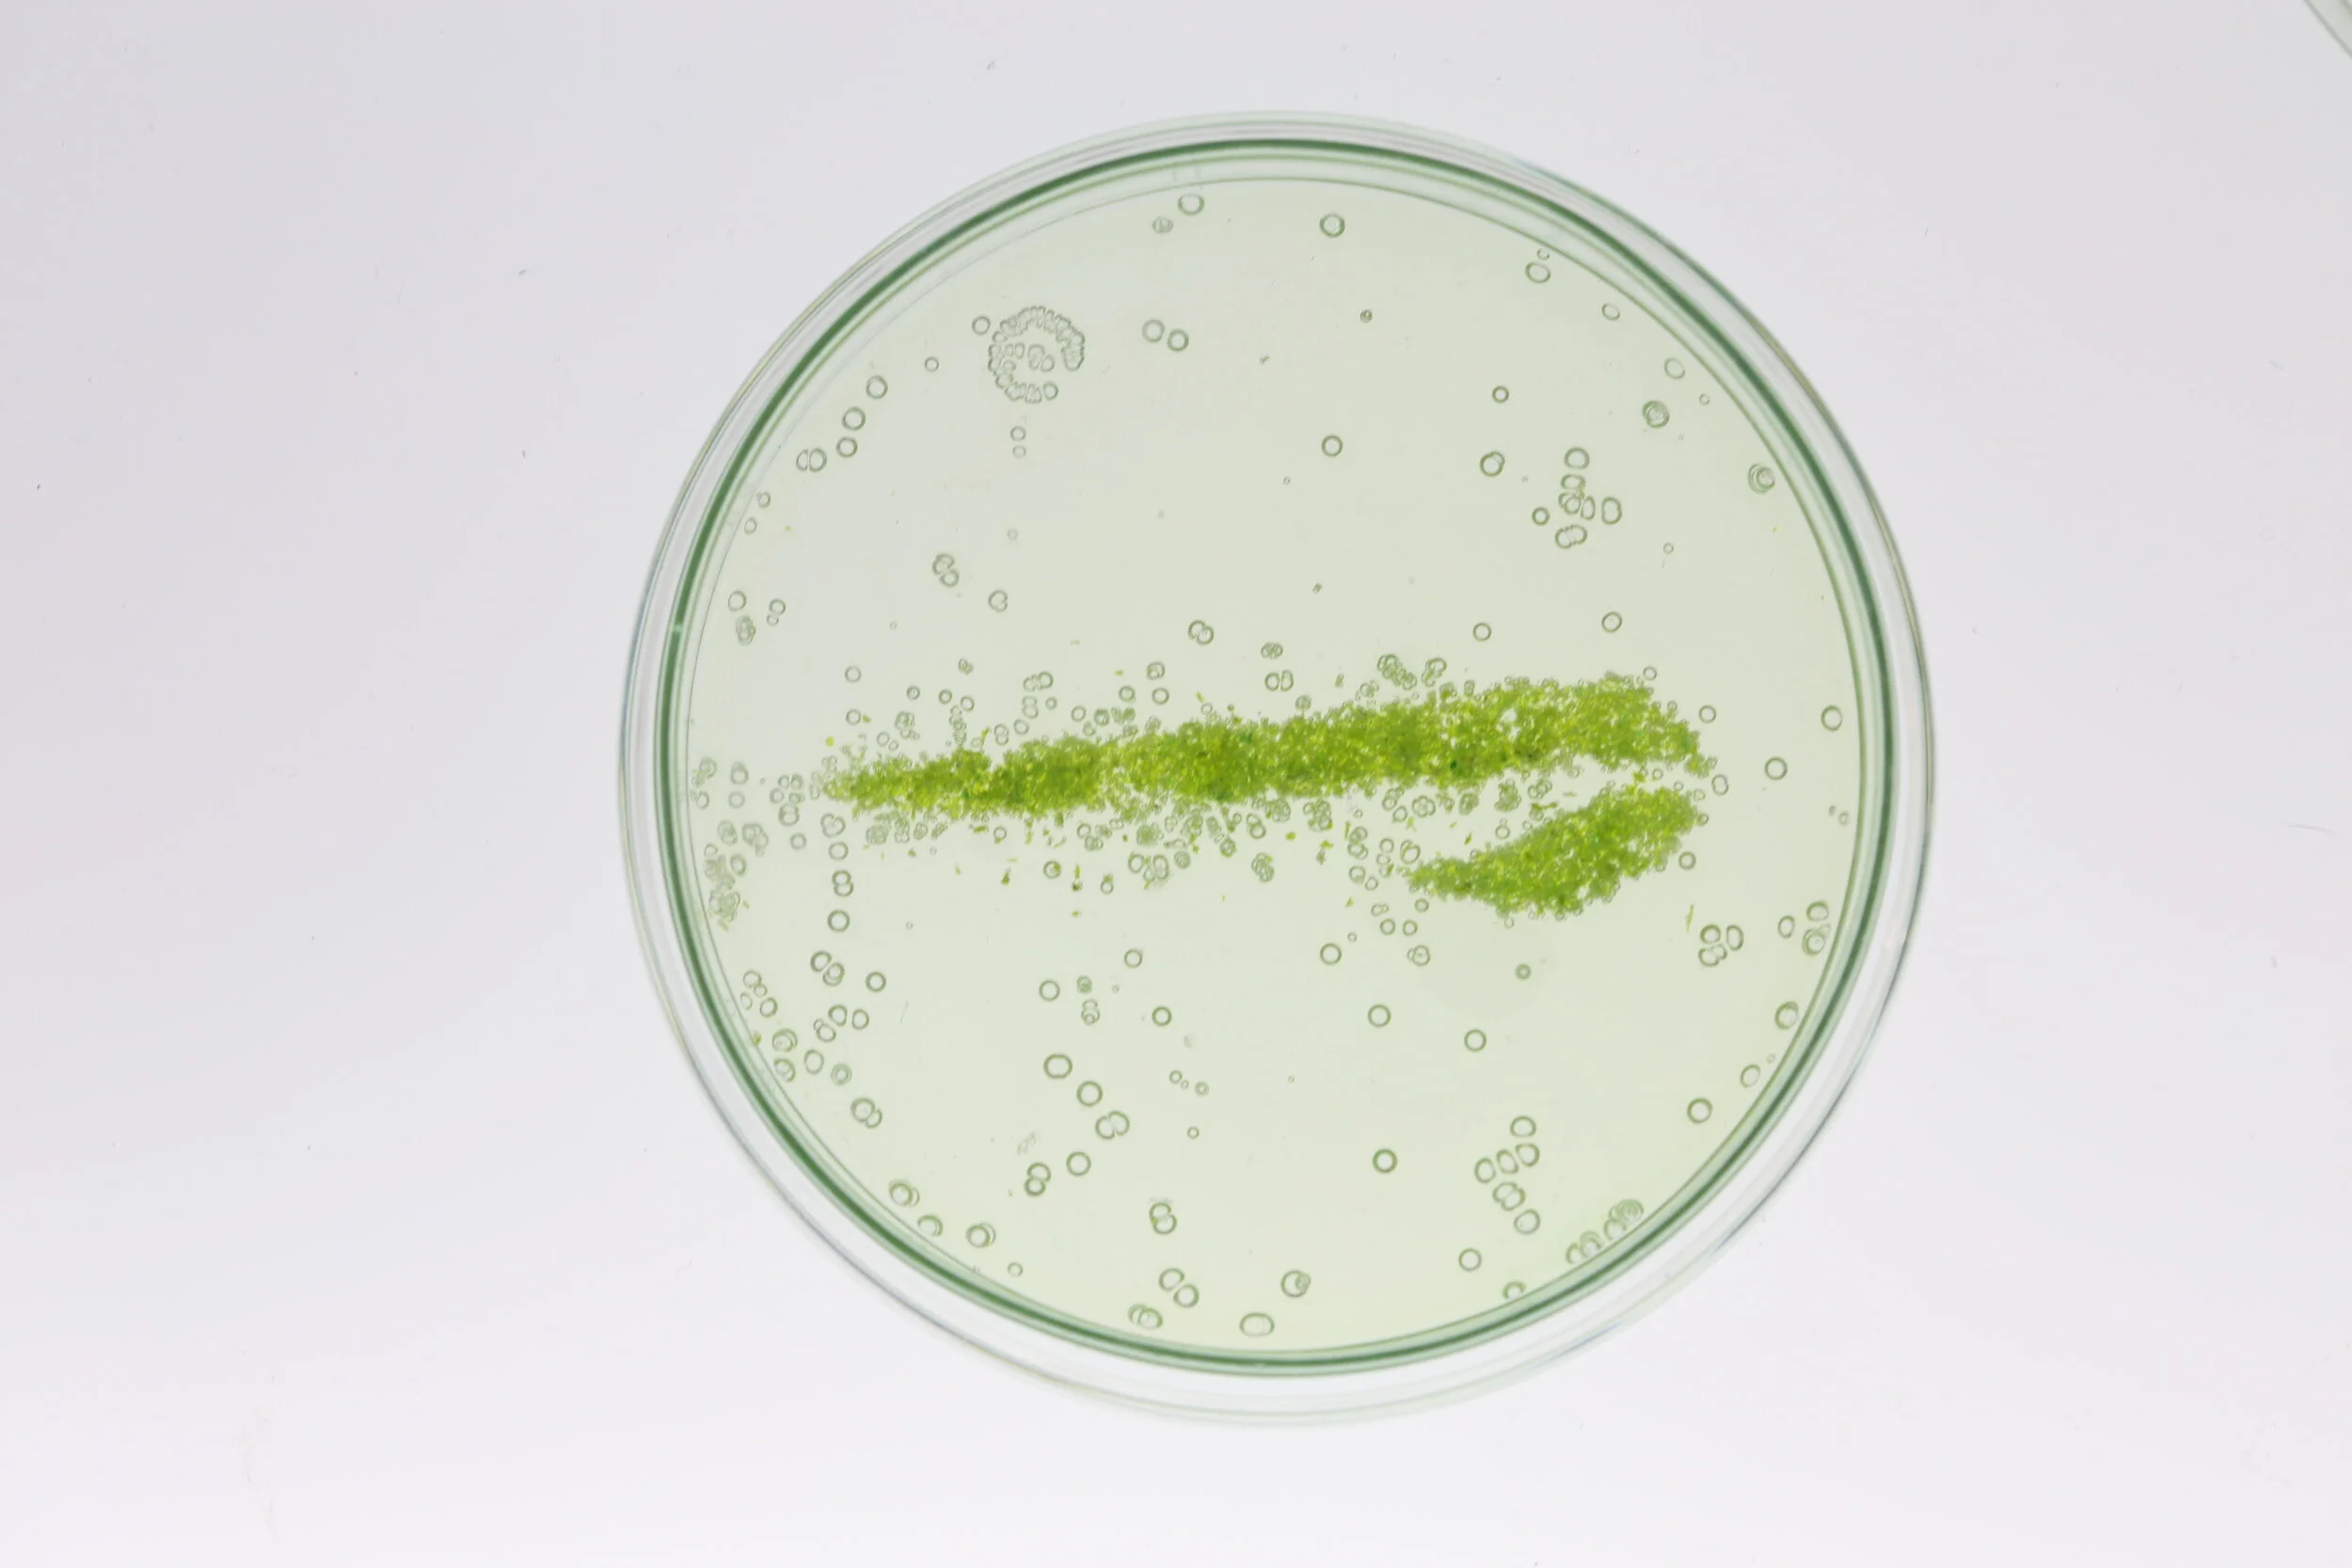

Aerium
Sustainable futures in aviation

Aerium
Exploring the Future of
Sustainable flight
2019
8 weeks
Role:
Conducted qualitative research and future forecasting with Experts,
Defined the Narrative and concept for the project,
Worked on all the electronics, experiements with algae,
and prototyping with generative design

The future of flying is green. Aerium imagines a future where synthetic biological systems are integrated seamlessly with electromechanical ones on board. This new industry of Bioavionics will challenge the way we experience flight, offering sustainable solutions for the air we breathe, the energy we consume and the water we drink.

Bioavionics
Recent developments and investments in synthetic biology, biotechnology, and genetics have made the design and production of biologically based systems more precise than ever. From algae powered homes to textile dyes from bacteria, these developments show great promise for designing a sustainable future.
Bioavionics integrates biological systems with electromechanical ones to hint at how it will impact our future experience of flight. Aerium is a multi-layered cabin structure that focuses on three systems: Hydration, Energy Generation, and Oxygenation.

Hydration
The first is a biopolymer coating on Aerium’s exterior microstructure. Inspired by the Namibian desert beetle, this responsive material harvests moisture and condensation from the clouds. It guides water towards the rear of the plane and collected for onboard clean water and grey water use.
This was represented by a section of the fuselage with a hydrophobic coating. Moisture on the surface trickled down the curved surface, and collected in a reservoir beneath.


Energy Generation and Oxygenation
The second layer is a computationally generated skeletal structure that minimises weight whilst maximising strength, saving fuel for each flight. Embedded in this generative structure is a synthetic chloroplast layer, extracted from algae and suspended on graphene matrices. Like plants, the organelles convert sunlight and CO2 expired by passengers to generate clean air and electricity through the process of photosynthesis.
The structure was shown through a computationally generated cross-section of the fuselage, Oxygenation was represented with a life size body panel of the plane, with the chloroplast layer integrated. To demonstrate the energy generation, we designed a 3 cell cabin light module that explored how people might interact with the avionics onboard.



Together, these layers are used to power avionics onboard, reducing stress on the primary fuel source. Currently, planes are inactive when parked at airports. With this new performative skin, we imagine a future where planes can become fuel cells both in air and on land, supplying excess clean water and energy for airports.


BA 2119: Flight of the Future
Aerium is a speculative design project by Hanson Cheng, Deepak Mallya, Julian Ellis-Brown & Mi Zhou. The project is a collaboration between the Royal College of Art and British Airways to celebrate the airline's centenary. and the brief was to imagine the next 100 years of flight. These future concepts were developed in collaboration with experts from Airbus, Boeing, Nasa’s Jet Propulsion Laboratories, Imperial Aeronautics and British Airways. The work was exhibited at the Saatchi Gallery “BA2119: Flight of the Future” exhibition in August 2019.

Press and Exhibitions:
Making & Learning
The project was divided into 4 phases of research, conceptualisation, prototyping and building. We decided to focus on the future of sustainability in aviation. The research phase identifying weak signal trends in innovation, going through piles of science research journals, conversations with experts and interviews with BA stakeholders from their position on sustainability. We then synthesised our insights to create the concept of bioavionics, and quickly got down to visualising its first big production.
We wanted to visualise the possible impact of biology, electronics and mechanics working together across scales. So we worked with micro algae. We grew the algae in pouches and integrated them into a scaled prototype of the arch. We also visualised various patterns in smaller scale prototypes. At the same time we experimented with bioplastics, superhydrophobic sprays, micro pumps and ultrasonic piezo induced vaporisers.
Major learning was A. To develop my ability as a designer to facilitate research, and conversations with people across different research areas. B. To synthesise inputs and identify patterns and trends in information to build a coherent narrative. C. To plan and build at a really high quality right down to the gracefully coordinated movements while building at a large scale.
Special Thanks to:
Dyson School of Design Engineering
Chandramohan George (Energy Technology and Systems)
Nasa Jet Propulsion Lab
Tibor Balint
Airbus
Tobias Meyer
Royal College of Art
Ashley Hall, Laura Ferrarelo